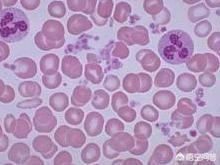

Les diabétiques souffrant de traumatismes peuvent-ils prendre de l'aspirine ?
Les diabétiques souffrant de traumatismes peuvent-ils prendre de l'aspirine ?
L'aspirine est le médicament de base le plus essentiel contre les maladies cardiovasculaires chez les diabétiques ; elle arrête la coagulation des plaquettes. Dans certains cas, si l'aspirine n'est pas arrêtée à temps, elle peut déclencher des saignements. L'aspirine est donc déconseillée à certaines personnes dans la situation suivante.

chirurgicales, ce qui peut entraîner des saignements au niveau de la plaie chirurgicale.
Patients ayant subi une extraction dentaire, qui s'est produite au cours du processus d'extraction.
Patients souffrant d'ulcères gastroduodénaux, entraînant une hémorragie gastroduodénale.
Patients présentant des hémorragies persistantes dues à des plaies traumatiques qui ne cicatrisent pas.
Déconseillé en cas de traumatisme et de risque d'hémorragie. Peut être utilisé à votre discrétion si vous avez un traumatisme cicatrisé sans risque de saignement.
J'espère que cela vous aidera.
Non. Les troubles de la coagulation sont généralement présents dans le diabète !
L'aspirine, également appelée acide acétylsalicylique, est un médicament antipyrétique et analgésique connu de longue date pour ses bons effets antipyrétiques et analgésiques. Il est utilisé pour le traitement des rhumes, de la fièvre, des maux de tête, des maux de dents, de l'arthralgie et des rhumatismes, et inhibe également l'agrégation plaquettaire. Il est utilisé dans la prévention et le traitement des cardiopathies ischémiques, de l'angine de poitrine, de l'infarctus cardio-pulmonaire et de la thrombose cérébrale. Il est également efficace dans l'angioplastie et le pontage, c'est pourquoi on l'appelle communément la "panacée".
En général, les analgésiques pour diabétiques en cas de traumatisme sont des analgésiques opioïdes tels que le Tramadol, le Dulcolax... mais ils nécessitent une ordonnance ! On ne peut pas les acheter en pharmacie car les opioïdes créent une dépendance !
Enfin, je vous souhaite une bonne santé.
Ces questions et réponses proviennent des utilisateurs du site, elles ne représentent pas la position du site, s'il y a une infraction, veuillez contacter l'administrateur pour la supprimer.